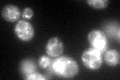
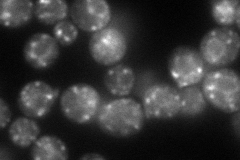
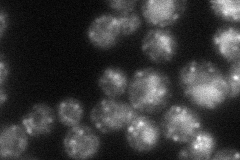
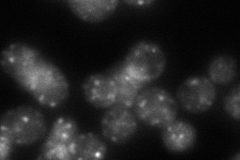
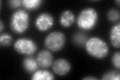

View description
Protein that forms a heterotrimeric complex with Erp2p, Emp24p, and Erv25p; member, along with Emp24p and Erv25p, of the p24 family involved in ER to Golgi transport and localized to COPII-coated vesicles
Localization:
Intensity:
Fold change:
Significance:
-
C’ GFP library in SD
vacuole membrane83.9 -
N' NOP1pr-GFP in SD
ER,punctate85.3228 -
N' TEF2pr-mCherry in SD
ER,punctate,vacuole37.0439 -
N' NATIVEpr-GFP in SD
punctate64.2941 -
N' TEF2pr-VC and Cyto-VN in SD

#N/A0 -
C’ GFP library in SD+DTT
vacuole membrane126.631.5Yes -
C’ GFP library in SD+H2O2

vacuole membrane70.990.84No -
C’ GFP library in Starvation Media

vacuole membrane25.750.3Yes -
C’ GFP library on the background of Pup2-DaMP

vacuole membrane -
C’ GFP library on the background of CCT mutant

vacuole membrane67.35580.802765No
